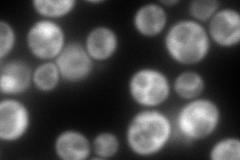
YLR048W
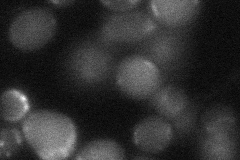
YLR048W
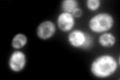
YLR048W

View description
Protein component of the small (40S) ribosomal subunit, nearly identical to Rps0Ap; required for maturation of 18S rRNA along with Rps0Ap; deletion of either RPS0 gene reduces growth rate, deletion of both genes is lethal
Localization:
Intensity:
Fold change:
Significance:
-
C’ GFP library in SD

cytosol917.23 -
N' NOP1pr-GFP in SD

cytosol182.878 -
N' TEF2pr-mCherry in SD
cytosol297.116 -
N' NATIVEpr-GFP in SD
punctate25.1307 -
N' TEF2pr-VC and Cyto-VN in SD

#N/A0 -
C’ GFP library in SD+DTT

cytosol868.80.94No -
C’ GFP library in SD+H2O2

cytosol868.240.94No -
C’ GFP library in Starvation Media
cytosol1176.181.28No -
C’ GFP library on the background of Pup2-DaMP

cytosol -
C’ GFP library on the background of CCT mutant

cytosol856.7360.934035No
